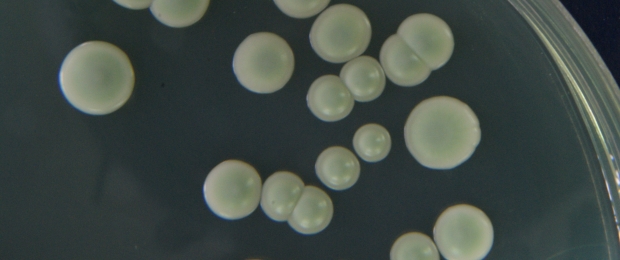

L'utilizzo di Lachancea thermotolerans per l'acidificazione naturale dei vini
Un articolo, pubblicato su Vitenda 2021, che spiega l'utilizzo di Lachancea thermotolerans per favorire e preservare l'acidità dei vini.
Bioprotezione in enologia
Un articlo che illustra il concetto di bioprotezione in ambito enologico e sottolinea la sua importanza per ridurre effetti indesiderati nel vino.

Solanum nigrum
Essenza erbacea che assume valore di infestante soprattutto nelle colture orticole e cerealicole, ma che si trova spesso anche nei vigneti sopratutto in quelli che hanno subito delle lavorazioni del terreno.

Ricevimento uva, pigiatura, torchiatura
Un articolo pubblicato su Vitenda 2020 che riassume e descrive le prime fasi operative; dal vigneto alla cantina, mettendo in evidenza: le problematiche, i costi e le diverse alternative. Per accedere all'articolo cliccare sull'immagine

Vendemmia meccanica
Lo sviluppo tecnologico ha permesso di migliorare tecnicamente le macchine vendemmiatrici soprattutto in termini: di maneggevolezza, di riduzione della perdita dl prodotto e di sanità dei grappoli.


